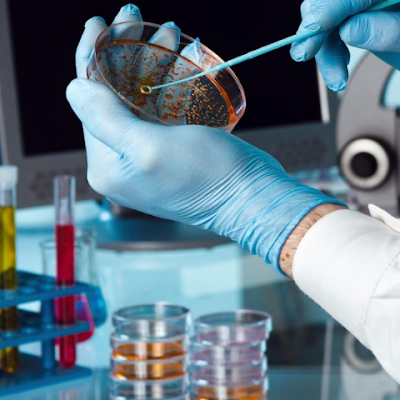
OlouaThiba10778's profile picture.

Innovation Santé
@BlogHuminno
Passionné par le corps humain, je partage sur mon compte X des actus consacrées aux innovations et découvertes en #Santé, #Biologie, #Handicap, #IA etc.
Pour davantage d'actualités, vous pouvez rejoindre mon Patreon patreon.com/c/Innovationsa…
patreon.com
Innovation santé | Patreon
Revue de presse de l'innovation en lien avec le corps humain
Des chercheurs créent des implants crâniens biorésorbables grâce à l’impression 3D #neurochirurgie #impression3d 3dnatives.com/implants-crani…!
3dnatives.com
Des chercheurs créent des implants crâniens biorésorbables grâce à l’impression 3D - 3Dnatives
Les neurochirurgiens de Dessau réalisent le premier implant crânien biorésorbable imprimé en 3D en Europe.
"Je suis aveugle et cette invention contribue à me rendre plus libre" france24.com/fr/%C3%A9missi…
france24.com
Tech 24 - "Je suis aveugle et cette invention contribue à me rendre plus libre"
Selon l’Organisation Mondiale de la Santé (OMS), près de 2,2 milliards de personnes dans le monde ont une déficience visuelle modérée à sévère. En France, on estime qu’environ 1,7 à 2 millions de...
❤️Le dispositif d'assistance cardiopulmonaire de l'Université de Lund (LUCAS) entrain d'effectuer des compressions thoraciques mécaniques sur un patient entre la vie et la mort
🇫🇷Atteinte de sclérose latérale amyotrophique, elle a pu remarcher grâce à un exosquelette #sla #maladiedeCharcot
🧠Des ingénieurs du Massachusetts Institute of Technology (MIT) ont développé un fil robotique magnétique conçu pour déboucher les vaisseaux sanguins du cerveau. #Neurosciences #innovation x.com/ali_alsama7i/s…
👶Atteinte d'une tumeur de la colonne vertébrale, cette petite fille a été extraite du ventre de sa mère pour être opérée. L'intervention terminée, les chirurgiens ont replacé l'enfant dans le ventre de sa mère. #Obstétrique
🇨🇭Première en Europe: le cœur d’un donneur a pu être conservé en dehors du corps durant près de 12 heures puis transplanté avec succès. (Pourquoi Docteur) #greffe #coeur #cardiologie

🇬🇧Des chercheurs britanniques ont mis au point un nouveau test qui détermine le risque de caillots sanguins chez les patients à risque. (Pourquoi Docteur) #innovation #médecine #santé

🇺🇸 C'est le 1er bébé au monde à être né 2 fois ! À mi-grossesse, Lynlee, atteinte d'une tumeur, a été extraite de l'utérus pour une opération. Puis, elle a été replacée dans le ventre de sa mère avant de naître 12 semaines plus tard. ❤ (Hashem AlGhaili) 📸 Paul Vincent Kuntz

🇫🇷Infertilité : des organoïdes de trompes de Fallope pourraient améliorer la PMA pourquoidocteur.fr/index.php?op=A… #Santé #Médecine #Innovation
pourquoidocteur.fr
Infertilité : des organoïdes de trompes de Fallope pourraient améliorer la PMA
Ces reproductions d’organes humains permettent de mieux conserver la mobilité des spermatozoïdes, en comparaison aux milieux de culture utilisés aujourd’hui. Cela pourrait améliorer les chances de...
🇰🇷BPCO, apnée du sommeil : Des scientifiques coréens ont élaboré un capteur de CO2 portable à faible consommation d'énergie et à grande vitesse, capable de surveiller la respiration de manière stable et en temps réel. (Pourquoi Docteur) #BPCO #Apnéedusommeil

🇬🇧Des enfants atteints de cécité génétique ont pu retrouver la vue en quelques années grâce à une thérapie génique mise au point par des chercheurs britanniques. Ce traitement visait à remplacer le gène défectueux AIPL1 dans la rétine. (Pourquoi Docteur) #cécité #génétique

🇯🇵Des chercheurs japonais sont parvenus à diagnostiquer plus précocement l'insuffisance rénale chronique en modifiant la méthode de calcul de l'hyperfiltration rénale. (Santelog) #néphrologie

🇺🇸Des bioingénieurs de l’Université de Floride ont entraîné une IA à analyser la déformation des traits du visage, en cas de douleur aiguë et à évaluer ainsi les niveaux de douleur. (Santelog) #IA

Les HUG créent la 1ère unité d’#ultrasonographie ciblée de Suisse. Elle est spécialisée dans l’imagerie par ultrasons au lit du malade. Dès 2027, sa maîtrise sera obligatoire pour le titre FMH @doctorfmh en médecine interne générale 👉hug.ch/actualite/mede… #innovation #médecine
L'IA débarque dans une parapharmacie Amazon "Il y a aujourd'hui une volonté d'individualiser le diagnostic" 💬 @DelteilPerfectC , vice-président du développement commercial Europe chez PerfectCorp 🎙️ @Fsorel
🇫🇷PROPSY, le programme de recherche qui va transformer la psychiatrie enseignementsup-recherche.gouv.fr/fr/propsy-le-p… #psychiatrie
United States Trends
- 1. Araujo 89.9K posts
- 2. Ferran 50.7K posts
- 3. Chelsea 390K posts
- 4. Barca 153K posts
- 5. Rashford 19.9K posts
- 6. Barcelona 292K posts
- 7. Kounde 22.7K posts
- 8. Rush Hour 4 15K posts
- 9. Godzilla 22.2K posts
- 10. #AskTems 3,473 posts
- 11. Cucurella 31.7K posts
- 12. Sonny Gray 8,368 posts
- 13. Enzo 41.6K posts
- 14. #CHEBAR 7,969 posts
- 15. Happy Thanksgiving 22.6K posts
- 16. Flick 24K posts
- 17. Raising Arizona 1,243 posts
- 18. National Treasure 6,321 posts
- 19. Caicedo 18.6K posts
- 20. Chalobah 6,368 posts
Something went wrong.
Something went wrong.